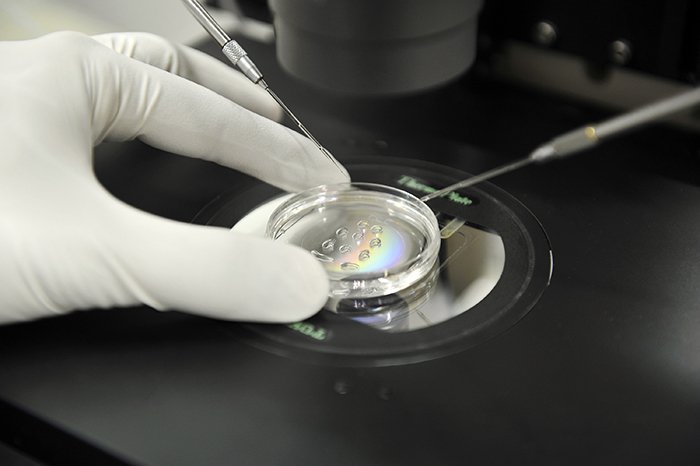

La transferencia de embriones eclosionados tras biopsia no altera su potencial de implantación.
La incorporación del test cromosómico completo (comprehensive chromosome screening, CCS) en el estadio de blastocisto ha supuesto un cambio muy importante en los laboratorios de fecundación in vitro (FIV). La transferencia de los embriones en fresco se suele demorar un día, hasta tener el diagnóstico cromosómico. Esto hace que muchos de los blastocistos hayan eclosionado completamente y tengan que ser transferidos o vitrificados en día 6 de desarrollo.
Uno de los aspectos que nos preocupaba enormemente es si los cambios introducidos en el laboratorio de FIV, podían suponer algún tipo de perjuicio, debido a las peculiaridades de estos tratamientos. La transferencia en día 6 de los embriones biopsiados en día 5 hace que muchos de ellos estén eclosionados. Esto supone una desprotección del embrión debido a la pérdida de la zona pelúcida (ZP) y algunas veces, la manipulación de estos embriones es más difícil. No obstante, a la luz de estos resultados, podemos concluir que no existen diferencias y que los embriones eclosionados implantan con las mismas opciones que lo hacen aquellos que presentan ZP.
Este trabajo es uno de las 11 investigaciones llevadas a cabo por nuestro grupo que han sido aceptadas por el comité científico de ASEBIR (Asociación española de biología de la reproducción) para su encuentro de bianual que tuvo lugar en noviembre
LA TRANSFERENCIA DE EMBRIONES ECLOSIONADOS TRAS BIOPSIA NO ALTERA SU POTENCIAL DE IMPLANTACIÓN. J. Ten, A. Rodríguez-Arnedo, J. Guerrero, M.C. Díaz, H. Blanca, J.A. Ortíz, B. Lledó, B. Moliner, J. Ll. Aparicio, R. Bernabeu. VIII Congreso ASEBIR. San Sebastián. Noviembre 2015